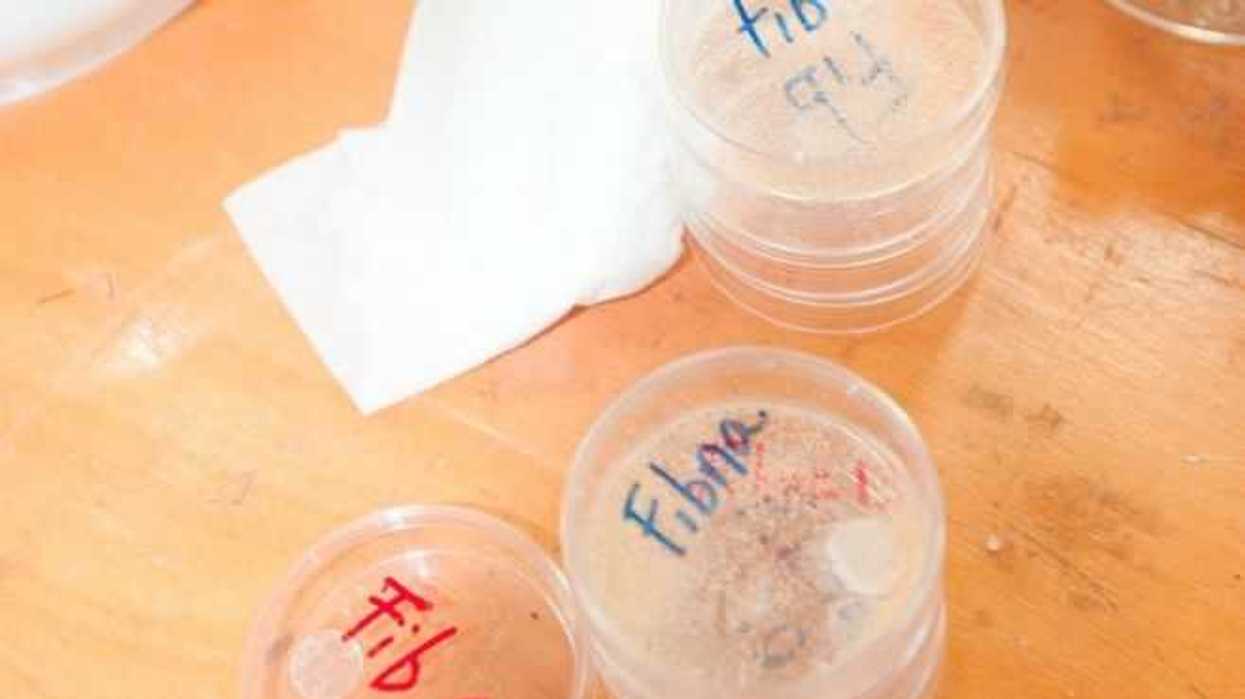
buscan-crear-tejido-cardiaco-y-piel-con-andamios.jpg

Mérida, 28 Jul (Notimex). - El Centro de Investigación Científica de Yucatán (CICY) se ha incorporado al campo de la ingeniería tisular con proyectos ambiciosos que buscan revolucionar la medicina como el desarrollo de tejido cardíaco y de piel a partir de un sistema de “andamios”.
Una de las cabezas de este proyecto es el doctor Fernando Hernández Sánchez, quien fabrica los “andamios” y que junto con otros especialistas de ese centro trabajan en el desarrollo de tejido cardiaco, piel y uretras, a través de las experiencias y conocimientos de la ingeniería tisular.
La ingeniería tisular constituye un conjunto de conocimientos, técnicas y métodos de base biotecnológica que permiten diseñar y generar en el laboratorio sustitutos tisulares, tejidos artificiales a partir de células madre y biomateriales.
Se considera que este tipo de biotecnología inició a finales de los años 70, aunque en realidad mucho de lo que conformaba esa área de investigación eran hipótesis y teorías que consistían en obtener células, hacerlas crecer y tratar de crear un nuevo tejido, pero no se lograba, explicó Hernández Sánchez en entrevista para Notimex.
En 1997 que se dio a conocer públicamente la fotografía de un ratón al que lograron unir una oreja en la parte del lomo, trabajo hecho por el grupo llamado “Vacanti” que operaba en la ciudad de Boston, Massachusetts, en Estados Unidos.
“Fabricaron una oreja con hilos de ácido poliláctico e insertaron células propias de un oído humano, y luego la oreja fue implantada en el lomo del ratón para que sus células alimentarán a su vez, a las células de la oreja y éstas empezarán a proliferar y reproducirse, lo que se logró”, recordó.
No era una oreja que se pudiera trasplantar, pero el hecho es que sí se pudo lograr crear tejidos y partir de ese logro, muchos especialistas en biomateriales, bioquímica y de otras disciplinas de todo el mundo han iniciado proyectos para dar soluciones a los grandes desafíos de la ciencia médica.
El entrevistado fabrica unos artefactos que se denominan “andamios” y que sirven como una especie de centro de cultivo celular hecho de bio-polímero que posteriormente sería insertado al paciente.
El desafío es tener las células, y ponerlas a trabajar en su reproducción en el andamio para que estas mismas creen su propia matriz extracelular.
Un ejemplo sencillo de su forma de operar sería que una persona perdió el pedazo de un hueso en un accidente, se hace una biopsia del hueso de esa misma persona , se sacan las células, y se dejan reproducir.
Luego se hace una limpieza para dejar únicamente las células troncales y esas se pasan a un “andamio”.
Una vez que penetran el andamio y empiecen a reproducirse, entonces el andamio se implanta en el cuerpo humano, y la idea es que conforme crezca la matriz extracelular, el andamio vaya desapareciendo hasta dar forma al pedazo de hueso que la persona requiere, añadió.
En los poco más de 20 años que lleva desarrollándose esta área de la ciencia, ya se han logrado crear por ejemplo uretras completas que son 100 por ciento funcionales, y ya hay avances importantes en el desarrollo de tejidos cutáneos.
De igual modo, comentó que se han logrado elaborar unos parches cardiacos que tenían como objetivo restablecer un corazón tras sufrir un infarto.
"Pero debido a la complejidad de los tejidos cardíacos, que están hechos para una labor específica y llevar un ritmo constante, éstos no fueron funcionales y por el contrario implicaban un riesgo para el usuario", refirió.
“Por ello, ahora sí que como sacado de una historia de ciencia ficción, surgió el reto de crear los corazones completos a través de las células del paciente para evitar un rechazo al trasplantar y tener una solución integral a quien ya tiene daños en su músculo cardíaco”, indicó.
“En el CICY ya estamos en esa línea, sabemos que podría llevar muchos años obtener un logro de esa magnitud, pero tenemos un gran equipo de especialistas dentro de la Unidad de Materiales, especialistas comprometidos con este y otros proyectos de ingeniería tisular que buscan revolucionar las ciencias médicas a través de los biomateriales”, expuso.
Una de las cabezas de este proyecto es el doctor Fernando Hernández Sánchez, quien fabrica los “andamios” y que junto con otros especialistas de ese centro trabajan en el desarrollo de tejido cardiaco, piel y uretras, a través de las experiencias y conocimientos de la ingeniería tisular.
La ingeniería tisular constituye un conjunto de conocimientos, técnicas y métodos de base biotecnológica que permiten diseñar y generar en el laboratorio sustitutos tisulares, tejidos artificiales a partir de células madre y biomateriales.
Se considera que este tipo de biotecnología inició a finales de los años 70, aunque en realidad mucho de lo que conformaba esa área de investigación eran hipótesis y teorías que consistían en obtener células, hacerlas crecer y tratar de crear un nuevo tejido, pero no se lograba, explicó Hernández Sánchez en entrevista para Notimex.
En 1997 que se dio a conocer públicamente la fotografía de un ratón al que lograron unir una oreja en la parte del lomo, trabajo hecho por el grupo llamado “Vacanti” que operaba en la ciudad de Boston, Massachusetts, en Estados Unidos.
“Fabricaron una oreja con hilos de ácido poliláctico e insertaron células propias de un oído humano, y luego la oreja fue implantada en el lomo del ratón para que sus células alimentarán a su vez, a las células de la oreja y éstas empezarán a proliferar y reproducirse, lo que se logró”, recordó.
No era una oreja que se pudiera trasplantar, pero el hecho es que sí se pudo lograr crear tejidos y partir de ese logro, muchos especialistas en biomateriales, bioquímica y de otras disciplinas de todo el mundo han iniciado proyectos para dar soluciones a los grandes desafíos de la ciencia médica.
Sin duda, entre los más ambiciosos dentro de la ingeniería tisular. esta el crear tejido cardíaco para fabricar corazones completos, piel u otros órganos, tejido óseo, o cualquiera de los cinco tejidos del cuerpo humano con las propias células del paciente, y el CICY ya se incorporó a esa tendencia.
El entrevistado fabrica unos artefactos que se denominan “andamios” y que sirven como una especie de centro de cultivo celular hecho de bio-polímero que posteriormente sería insertado al paciente.
El desafío es tener las células, y ponerlas a trabajar en su reproducción en el andamio para que estas mismas creen su propia matriz extracelular.
Un ejemplo sencillo de su forma de operar sería que una persona perdió el pedazo de un hueso en un accidente, se hace una biopsia del hueso de esa misma persona , se sacan las células, y se dejan reproducir.
Luego se hace una limpieza para dejar únicamente las células troncales y esas se pasan a un “andamio”.
Una vez que penetran el andamio y empiecen a reproducirse, entonces el andamio se implanta en el cuerpo humano, y la idea es que conforme crezca la matriz extracelular, el andamio vaya desapareciendo hasta dar forma al pedazo de hueso que la persona requiere, añadió.
En los poco más de 20 años que lleva desarrollándose esta área de la ciencia, ya se han logrado crear por ejemplo uretras completas que son 100 por ciento funcionales, y ya hay avances importantes en el desarrollo de tejidos cutáneos.
De igual modo, comentó que se han logrado elaborar unos parches cardiacos que tenían como objetivo restablecer un corazón tras sufrir un infarto.
"Pero debido a la complejidad de los tejidos cardíacos, que están hechos para una labor específica y llevar un ritmo constante, éstos no fueron funcionales y por el contrario implicaban un riesgo para el usuario", refirió.
“Por ello, ahora sí que como sacado de una historia de ciencia ficción, surgió el reto de crear los corazones completos a través de las células del paciente para evitar un rechazo al trasplantar y tener una solución integral a quien ya tiene daños en su músculo cardíaco”, indicó.
“En el CICY ya estamos en esa línea, sabemos que podría llevar muchos años obtener un logro de esa magnitud, pero tenemos un gran equipo de especialistas dentro de la Unidad de Materiales, especialistas comprometidos con este y otros proyectos de ingeniería tisular que buscan revolucionar las ciencias médicas a través de los biomateriales”, expuso.

Meizu Lucky 08 5G: diseño simétrico y una pantalla impresionante.
Meizu Lucky 08 5G: diseño simétrico y una pantalla impresionante.
Meizu Lucky 08 5G: diseño simétrico y una pantalla impresionante.


Editor de video gratuito que extrae momentos destacados de transmisiones largas.
Editor de video gratuito que extrae momentos destacados de transmisiones largas.
Editor de video gratuito que extrae momentos destacados de transmisiones largas.
Editor de video gratuito que extrae momentos destacados de transmisiones largas.
Editor de video gratuito que extrae momentos destacados de transmisiones largas.
Editor de video gratuito que extrae momentos destacados de transmisiones largas.